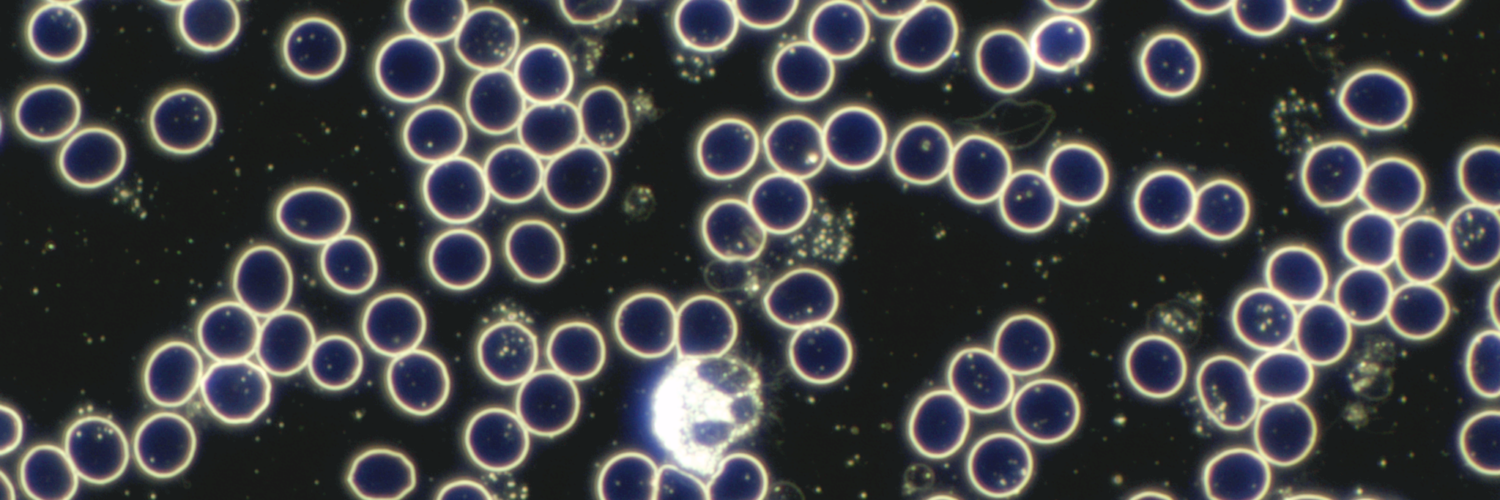
Dunkelfeld2

Dunkelfeldmikroskopie
„Blut ist ein ganz besonderer Saft.“
– J.W. von Goethe –
Die Dunkelfeldmikroskopie ist ein faszinierendes Verfahren, das einen einzigartigen Einblick in die Qualität unseres Blutes bietet. Anders als herkömmliche Blutuntersuchungen ermöglicht die Dunkelfeldmikroskopie eine detaillierte Betrachtung lebender Blutzellen in ihrem natürlichen Zustand. Dabei werden winzige Veränderungen und Unregelmäßigkeiten sichtbar, die auf mögliche Gesundheitsprobleme hinweisen können.
Was ist eine Dunkelfeldanalyse?
Die Dunkelfeldanalyse ist eine spezielle Form der Blutuntersuchung, bei der ein Tropfen Blut unter einem Mikroskop mit Hilfe einer speziellen Belichtungsart betrachtet wird. Im Gegensatz zu herkömmlichen Bluttests, bei denen das Blut vorher gefärbt wird, betrachtet die Dunkelfeldmikroskopie das lebendige Blut in seinem natürlichen Zustand.
Die Vorteile im Überblick:
Erkennung von Belastungen im Milieu
Ganzheitliche Betrachtung
Individuelle Gesundheitsvorsorge
Eine Vitalblutanalyse mittels Dunkelfeldmikroskopie ist somit ein Schlüssel zur proaktiven Gesundheitspflege. Indem sie frühzeitig auf Ungleichgewichte im Organismus hinweist, ermöglicht sie individuell angepasste Maßnahmen zur Förderung von Wohlbefinden und Vitalität.
Bitte beachten Sie, dass die Untersuchung des Blutes im Dunkelfeld keine schulmedizinische Untersuchung ersetzt.